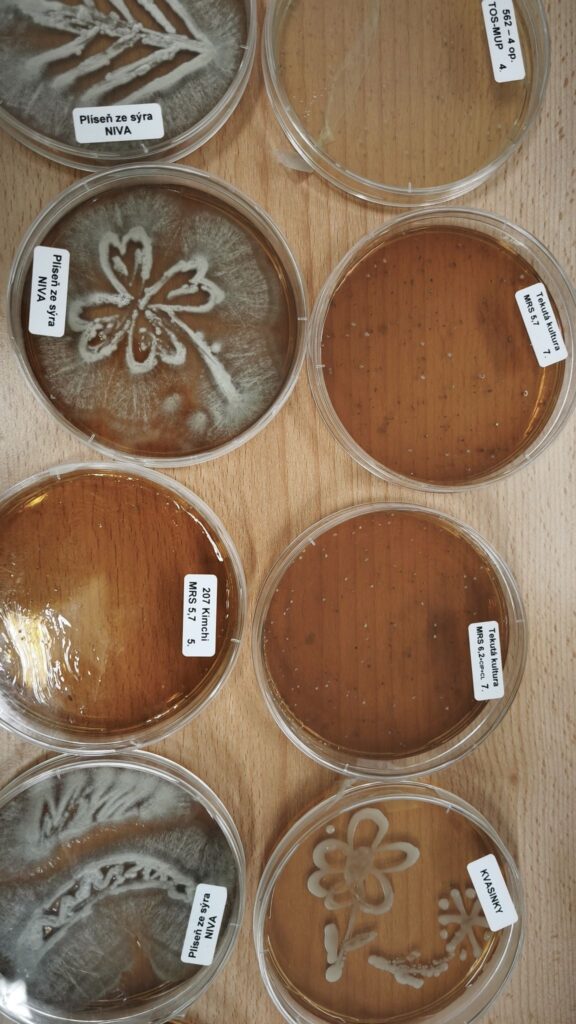
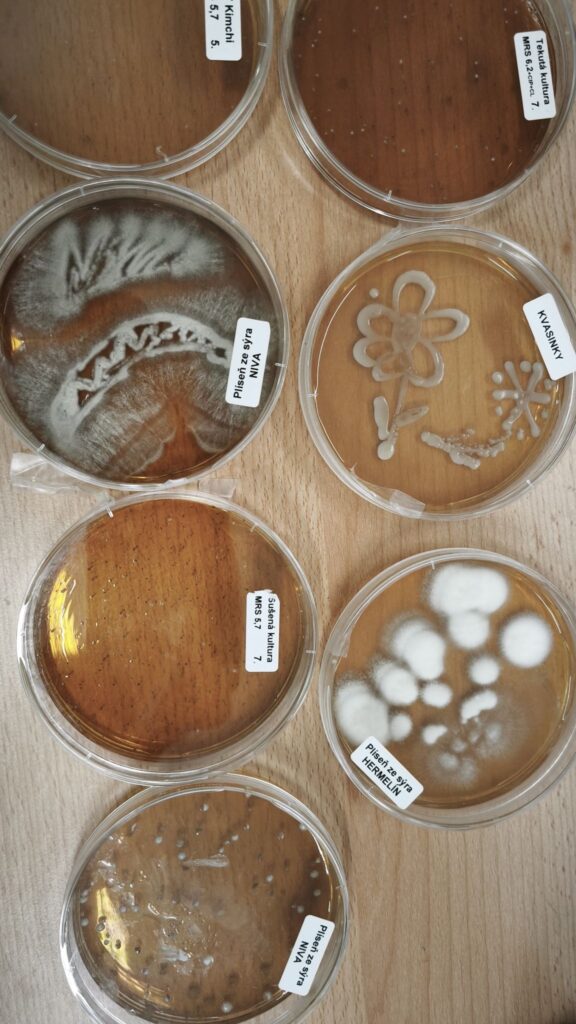

Dovolujeme si Vás srdečně pozvat na tradiční online workshop České akademie zemědělských věd (ČAZV) s názvem „Piš a publikuj aneb Jak připravit rukopis pro vědecký časopis“, který se uskuteční dne 12. května 2026 od 13:00 do 15:00 hodin.
Členka Odboru potravinářské technologie a techniky (OPTT) ČAZV Ing. Ivana Hyršlová se společně s kolegyní z Výzkumného ústavu mlékárenského podílela na realizaci vzdělávacího programu pro děti z Dětské zemědělské akademie v Klatovech.
Během interaktivní přednášky se děti seznámily s fascinujícím světem mikroorganismů – dozvěděly se, co mikroorganismy jsou, kdo je jako první objevil a jak významnou roli hrají v našem každodenním životě. Děti dále zjistily, že mezi mikroorganismy najdeme nejen „hodné“, ale i méně přátelské zástupce, a že každý člověk má svůj jedinečný mikrobiom. Zároveň si uvědomily, že bez mikroorganismů by nevznikla řada běžných potravin, jako jsou sýry, jogurty nebo kvašené nápoje.
Program byl doplněn o praktickou část, během níž si děti vyzkoušely výrobu kimči a seznámily se s dalšími fermentovanými produkty, například kombuchou nebo vodním kefírem, při jehož výrobě se využívají tzv. tiby krystaly. Nechyběla ani hravá aktivita v podobě ankety o nejoblíbenější plyšový mikroorganismus, ve které zvítězil Lactobacillus.
Akce je příkladem aktivního zapojení členů ČAZV do popularizace vědy a vzdělávání mladé generace. Velké poděkování patří přednášejícím za skutečně inspirativní program.